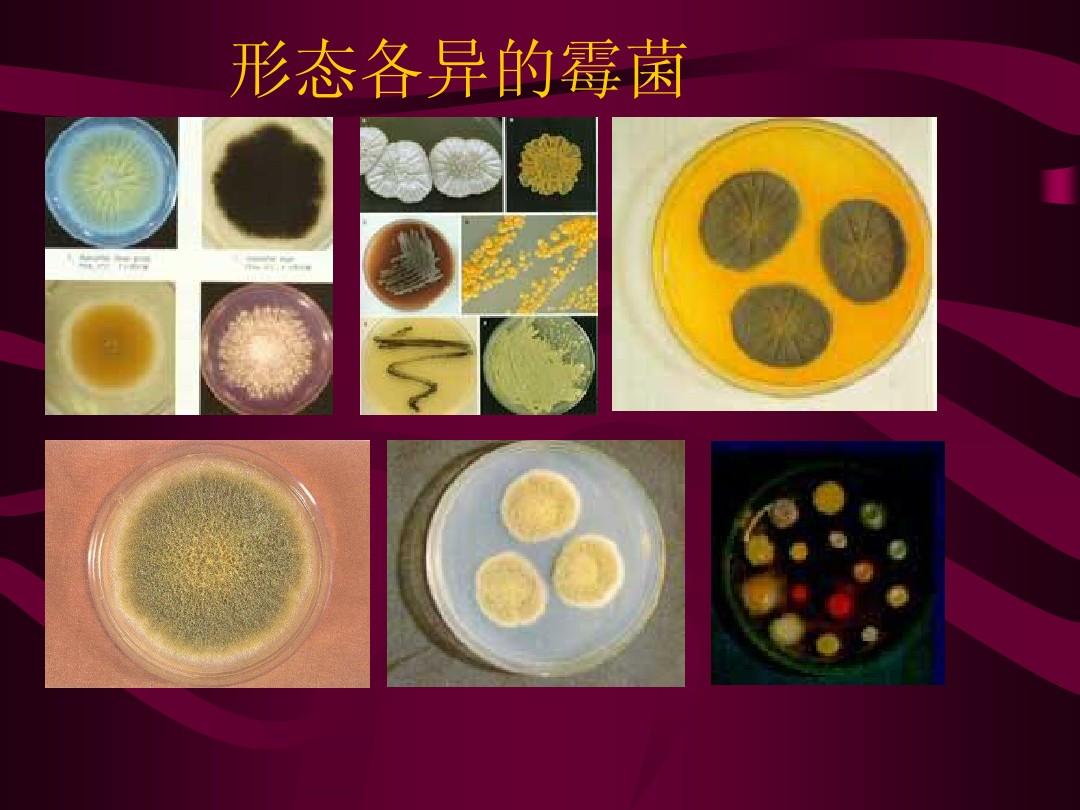

發(fā)布時間:2021-07-02 來源:乃氏新材料
飼料及其原料在加工,儲存和運輸過程中容易發(fā)生霉變,霉菌不僅污染飼料,而且消耗飼料中的營養(yǎng)物質(zhì),使飼料品質(zhì)下降,畜禽攝食了受霉菌毒素污染的飼料之后容易出現(xiàn)中毒,腹瀉,生長和繁殖性能下降等癥狀,嚴(yán)重情況下可能導(dǎo)致死亡。那么飼料中霉菌毒素如何脫毒呢?
1. 物理降解法:
應(yīng)用加熱的方法,或者結(jié)合應(yīng)用加熱和加壓,尤其在潮濕的條件下,可破壞大多數(shù)霉菌毒素。
2. 物理吸附法:
在飼料中添加可以吸附霉菌毒素的物質(zhì),使毒素的在經(jīng)過動物腸道時不被動物所吸收,直接排除動物體。 目前用于物理吸附的物質(zhì)主要有:鋁硅酸鹽類,活性炭,酵母,酵母的細(xì)胞壁成分等。
3. 生物學(xué)法:
生物學(xué)去毒法是篩選某些微生物,利用其生物轉(zhuǎn)化作用,使霉菌毒素破壞或轉(zhuǎn)變?yōu)榈投疚镔|(zhì)的方法。